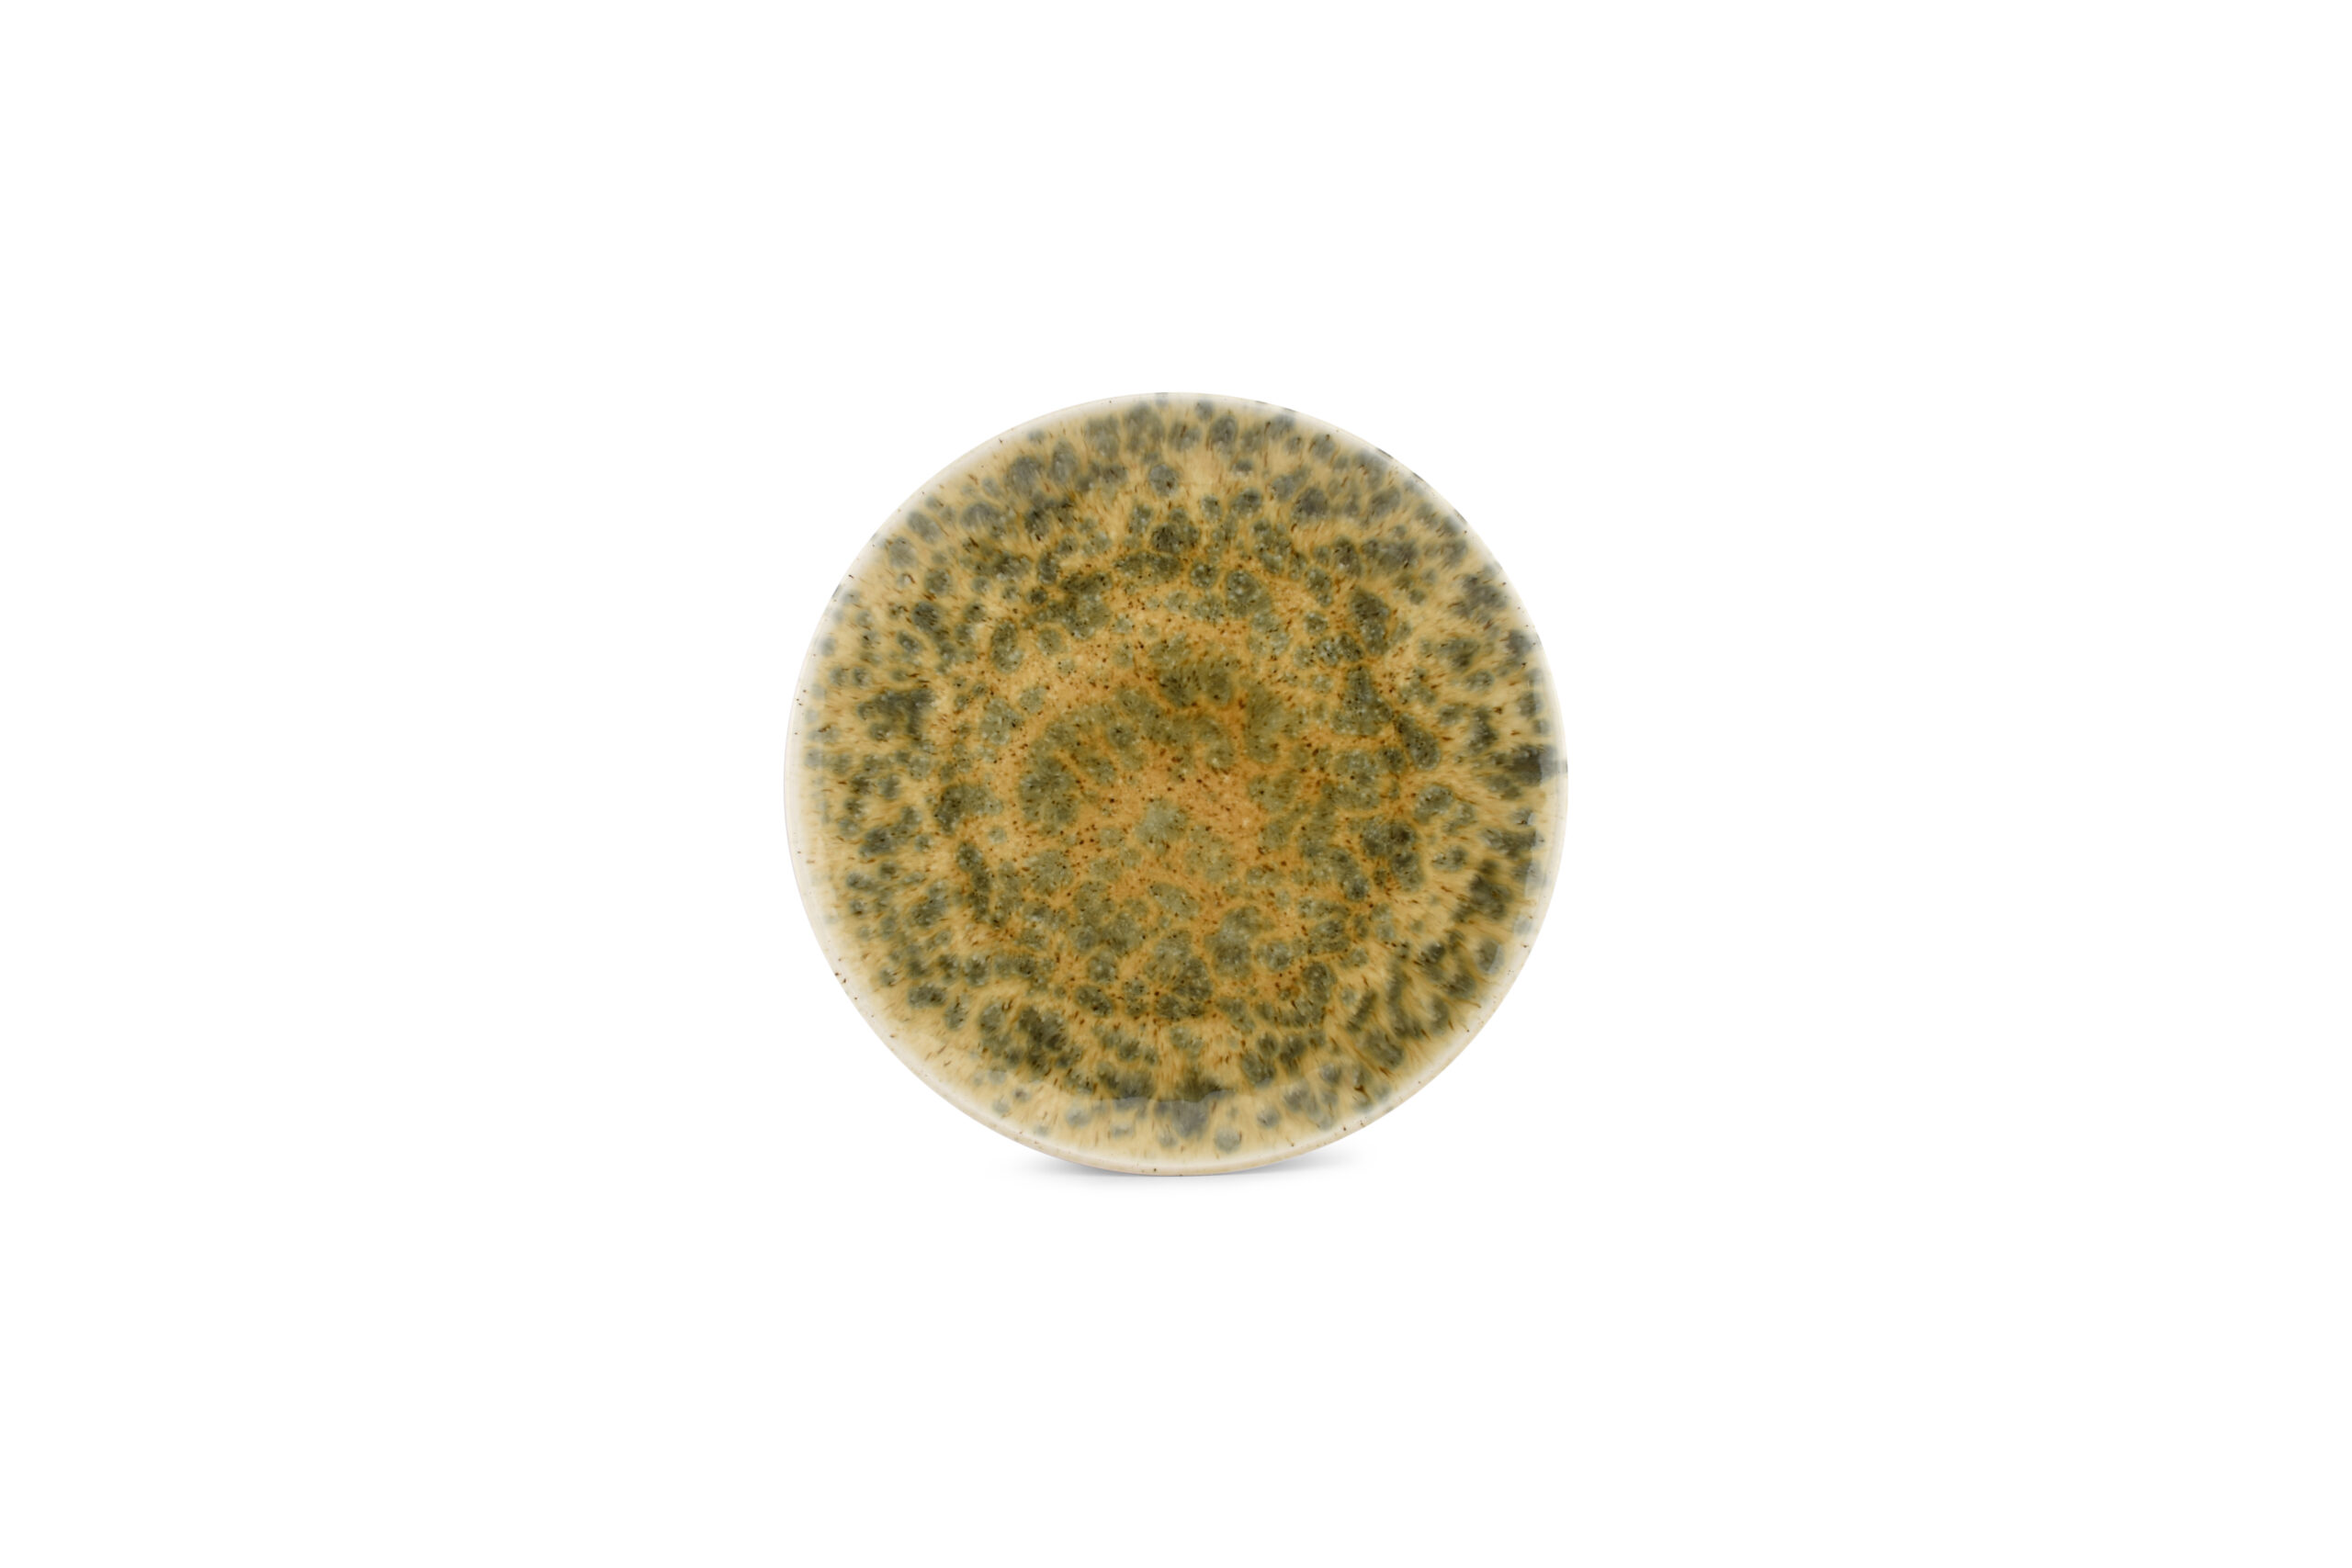

Bowl laag 17,5 Escura dark brown
Bowl laag 17,5 Escura dark brown
Oorspronkelijke prijs was: € 9,95.€ 7,96Huidige prijs is: € 7,96.
Bowl laag 17,5 Escura dark brown.
Deze bijzondere serie ziet er niet alleen erg Fancy uit, wat deze Escura lijn zo bijzonder maakt is dat ieder bord z’n eigen identiteit heeft.
Elk bord heeft z’n eigen kleurschakering….kunststukjes op zich die vragen om fantastische gerechten.
Beschrijving
Bowl laag 17,5 Escura dark brown.
De doorsnede is 17,5x H3,5cm
Gemaakt van Porselein.
Deze bijzondere serie ziet er niet alleen erg Fancy uit, wat deze Escura lijn zo bijzonder maakt is dat ieder bord z’n eigen identiteit heeft. Elk bord heeft z’n eigen kleurschakering….kunststukjes op zich die vragen om fantastische gerechten.

Beoordelingen
Er zijn nog geen beoordelingen.